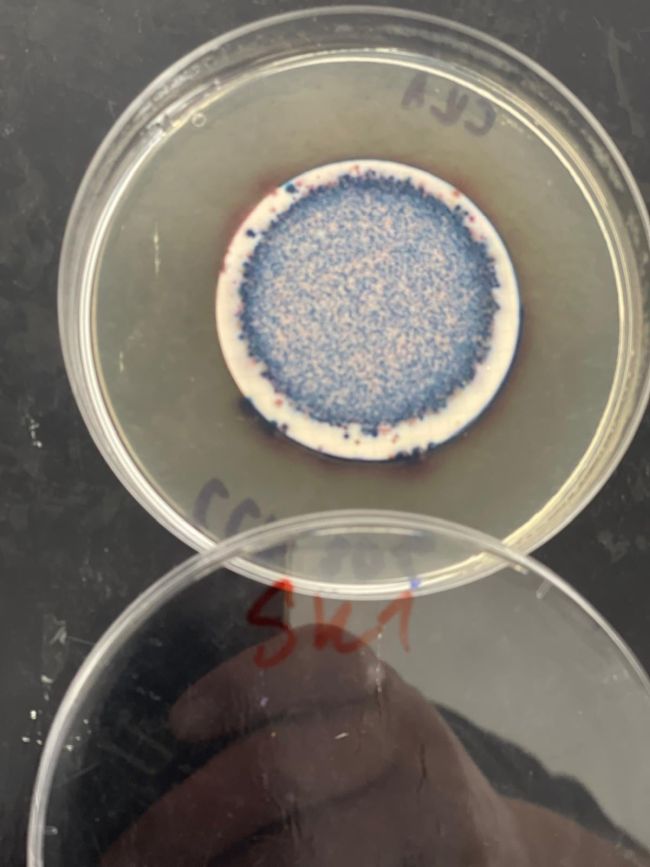

Христо Димитриевски спроведе истражување за микробиолошкиот диверзитет во реката Вардар. Притоа, посебен фокус беше ставен на утврдување на присуството и преносот на фекални и индикаторни бактерии од реката кон околните почви, со цел да се процени потенцијалниот ризик за безбедноста на храната и јавното здравје
Какво е влијанието на човекот врз микробиолошкиот диверзитет на реката Вардар? Како загадените води влијаат врз почвата, производството на храна на околната почва и јавното здравје? Во рамките на Програмата за поддршка на млади еколози „Д-р Љупчо Меловски“ на Македонско еколошко друштво, студентот Христо Димитриевски спроведе истражување за микробиолошкиот диверзитет на реката Вардар. Притоа, посебен фокус беше ставен на утврдување на присуството и преносот на фекални и индикаторни бактерии од реката кон околните почви, со цел да се процени потенцијалниот ризик за безбедноста на храната и јавното здравје.

- Клучната порака е дека загадувањето на реките не е изолиран еколошки проблем, тоа директно влијае врз почвите, земјоделството, безбедноста на храната и јавното здравје. Микробиолошкото загадување, иако често невидливо, има реални и долгорочни последици. Ова истражување повикува на поголема институционална одговорност, подобрување на системите за прочистување на отпадни води и интегриран мониторинг на водените и почвените екосистеми. Воедно, има цел да ја подигне јавната свест дека заштитата на реките значи заштита на целокупните екосистеми и на луѓето што зависат од нив - истакнува Христо.
Загадена вода, загадено и околното копно
Истражувањето беше реализирано како соработка на Природно-математичкиот факултет во Скопје и Истражувачки центар за применета микробиологија и биотехнологија „ИЦПМБ д-р Кунгуловски“.

- Главната мотивација за ова истражување беше видливиот и долготраен процес на загадување на реката Вардар од страна на луѓето, особено преку испуштање непрочистени отпадни води и интензивното земјоделство по нејзиниот тек. Иако хемиското загадување често е предмет на јавна дискусија, микробиолошкото загадување, особено фекалната контаминација, сè уште е недоволно застапено, и покрај неговото директно влијание врз екосистемите и човековото здравје. Во рамките на МЕД проектот применивме мултидисциплинарен пристап, комбинирајќи систематско земање примероци од речна вода со примероци од почви од земјоделски површини во близина на речното корито. Истражувањето го следеше текот на реката надолжно, од изворот кон пониските делови, што ни овозможи да ги следиме просторните промени во микробиолошките заедници. Лабораториските анализи беа насочени кон фекални индикаторни бактерии и други микробиолошки параметри. Истражувањето бараше континуирана посветеност во период од неколку месеци, вклучувајќи теренска работа, лабораториска анализи, обработка на податоци и нивна интерпретација - ни сподели Христо.

Еден од најзначајните наоди од истражувањето е јасното зголемување на концентрациите на фекални и индикаторни бактерии од горните делови на реката кон нејзините пониски текови. Овој тренд е силно поврзан со зголемената урбанизација, земјоделски површински истекувања и недоволно ефикасно прочистување на отпадните води.
- Еднакво значајно е и откривањето на истите бактерии во околните земјоделски почви, што покажува дека загадувањето на реката не останува ограничено само на водниот екосистем, туку се пренесува и во соседните копнени екосистеми. Овие резултати јасно укажуваат дека антропогениот фактор создава поврзан пат на контаминација помеѓу водата и земјоделските површини во непосредна околина - вели Христо.
Наодите укажуваат на системски проблем
Како и кај многу теренски еколошки истражувања, логистичките предизвици беа неизбежни и во истражувањето на Христо Димитриевски.
- Пристапот до одредени локации за земање примероци, обезбедувањето конзистентни услови за примероците и координацијата на лабораториската работа бараа внимателно планирање. Дополнително, микробиолошките анализи бараат строги протоколи и високо ниво на прецизност, што често е временски интензивно. Најголемото изненадување беше степенот до кој фекалната контаминација беше присутна и во околните почви, дури и на локации кои визуелно изгледаа „чисти“. Ова потврди дека микробиолошкото загадување често е невидливо и потценето, но истовремено упорно и широко распространето - истакнува тој.
Од аспект на јавното здравје, овој тренд е исклучително загрижувачки. Фекалните индикаторни бактерии укажуваат на можноста за присуство на патогени микроорганизми кои можат да предизвикаат гастроинтестинални и други инфекции. Заедниците што ја користат речната вода за наводнување, рекреација или индиректен контакт се изложени на зголемен здравствен ризик. Наодите укажуваат на системски проблем, а не на изолирани случаи на загадување, што ја нагласува потребата од подобро управување со отпадните води и постојано микробиолошко следење.
- Присуството на фекални бактерии во земјоделските почви претставува сериозна загриженост за безбедноста на храната, особено кај културите кои се консумираат свежи или со минимална преработка. Контаминираната вода за наводнување може да внесе штетни микроорганизми во почвата, каде што тие можат да опстојуваат и потенцијално да ги контаминираат земјоделските производи. Во региони како Валандово, каде што земјоделството има клучно економско значење, овие резултати ја нагласуваат потребата од безбедни практики за наводнување и редовна микробиолошка процена на водата и почвата што се користат за производство на храна - подвлекува Христо.
Загадената вода го менува природниот микробиом
Загадената речна вода го менува природниот микробиом и структурата на почвите преку внесување несвојствени и потенцијално патогени микроорганизми. Ова ја нарушува постојната микробиолошка рамнотежа, која е од суштинско значење за плодноста на почвата, циркулацијата на хранливи материи и здравјето на растенијата. На долг рок, ваквите нарушувања можат да ја намалат отпорноста на почвите, да влијаат врз продуктивноста на земјоделските култури и да ја ослабнат стабилноста на екосистемите. Здравите почви зависат од балансирана микробиолошка заедница, а континуираното загадување ја загрозува таа рамнотежа, објаснува Христо.
Програмата за поддршка на млади еколози „Д-р Љупчо Меловски“ има клучна улога во јакнењето на младите истражувачи, обезбедувајќи и финансиска поддршка и професионална афирмација.

- Ваквите програми се од суштинско значење за создавање нова генерација еколошки научници кои се подготвени да одговорат на сложените, реални еколошки предизвици преку истражување засновано на научни докази. Лабораториската работа беше реализирана во научноистражувачкиот центар за микробиологија и микробна биотехнологија „ИЦПМБ д-р Кунгуловски“. Во таа насока, сакам да изразам искрена и длабока благодарност до проф. д-р Џоко Кунгуловски, кој со своето долгогодишно искуство и стручност во областа на микробиологијата и микробната екологија, како и до мојот ментор м-р Игор Павловски, ме поддржаа и ми ги овозможија неопходните услови за успешно реализирање на ова истражување. Оваа соработка има исклучително значење, не само за мојот академски и научен развој, туку и за сите студенти и млади истражувачи кои имаат интерес и мотивација да се вклучат во научноистражувачка работа и да придонесат кон развојот на науката - истакна нашиот соговорник.
Фото: приватна архива
Оваа содржина е заштитена со авторски права. Фотографиите се од сопствени извори или од платени сервиси. Секоја употреба, копирање, преземање, репродукција или дистрибуција, целосна или делумна, без претходна писмена дозвола од редакцијата, е строго забранета и подлежи на законска одговорност. Бесплатно преземање е можно само на првата третина од текстот, со јасно наведен извор и линк до изворниот текст во првата реченица. Факултети.мк ги почитува професионалните/етичките стандарди, Кодексот на новинарите и Принципите на Меѓународната федерација на новинарите.